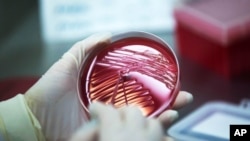
CDC coronavirus. US Consulate General HCMC

Giám đốc Trung tâm Kiểm soát bệnh tật Hà Nội, Tiến sĩ Nguyễn Nhật Cảm đã bị bắt tạm giam vào chiều ngày 22/4 về những sai phạm trong mua sắm thiết bị y tế phòng dịch, truyền thông Việt Nam đồng loạt đưa tin.
Hãng tin Reuters cho biết tất cả có 7 người bị bắt trong đó có 3 cán bộ của Trung tâm Kiểm soát bênh tật Hà Nội, về cáo trạng nâng khống giá trị một hệ thống xét nghiệm Covid-19, “gây thiệt hại nghiêm trọng cho Nhà nước.”
Cổng Thông tin Chính phủ - Bộ Công an nói căn cứ trên kết quả điều tra và các chứng cứ thu thập được, Cơ quan Cành sát điều tra Bộ Công an (C03) đã ra Quyết định khởi tố vụ án hình sự “Vi phạm quy định về đấu thầu gây hậu quả nghiêm trọng.”
Bộ Công An cho biết trong quá trình điều tra, CO3 đã xác định các đối tượng “cấu kết, gian lận, thông đồng, nâng khống giá trị gói thầu mua sắm Hệ thống Realtime PCR tự động - xét nghiệm Covid-19, gây thiệt hại nghiêm trọng cho Nhà nước.”
Bộ Công An xác nhận danh tính những người bị bắt gồm; Tiến sĩ Nguyễn Nhật Cảm, Giám đốc CDC Hà Nội, bà Nguyễn Vũ Hà Thanh, Trưởng phòng Tài chính kế toán CDC, Lê Xuân Tuấn, nhân viên Phòng Tài chính kế toán (CDC); Ông Đào Thế Vinh, Giám đốc Công ty TNHH Vật tư khoa học và Thương mại Việt Nam, ông Nguyễn Trần Duy, Tổng Giám đốc Công ty cổ phần định giá và bán đấu giá tài sản Nhân Thành, ông Nguyễn Ngọc Nhất, nhân viên Công ty TNHH Phát triển khoa học Vitech, và ông Nguyễn Thanh Tuyền, nhân viên Công ty TNHH Thiết bị y tế Phương Đông.
VNN cho biết Cơ quan Cành sát điều tra Bộ Công an đã thi hành quyết định khởi tố và các lệnh khám xét và bắt tạm giam các bị can “theo đúng quy định của pháp luật, sau khi được Viện Kiểm sát nhân dân tối cao phê chuẩn”.
Hãng tin Reuters nói Trung tâm Kiểm soát bệnh tật Hà Nội chưa đưa ra bình luận nào về tin này.